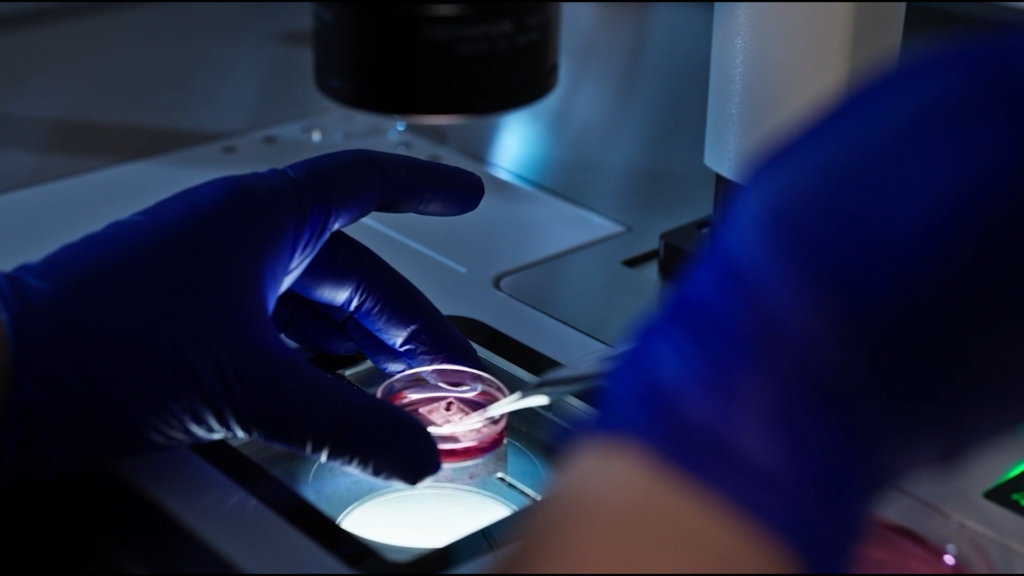

18.03.2026 21:15
Tüp bebek tedavisi sadece tıbbi bir müdahale değil, aynı zamanda yaşam tarzında değişiklik yapmayı gerektiren bir süreç. Medipol Sağlık Grubu Kadın Hastalıkları ve Doğum Uzmanı Doç. Dr. Aysu Akça, üreme hücrelerinin yaşam alışkanlıklarından doğrudan etkilendiğini belirterek, sigara kullanımı ve beslenme düzeninin tedavi başarısı üzerinde kritik rol oynadığını vurguladı.
Başarılı bir tüp bebek tedavisi, yalnızca doktorun değil, çiftin de katkısıyla mümkün oluyor. Medipol Mega Üniversite Hastanesi’nden Doç. Dr. Akça, sigara ve sağlıksız beslenmenin tedavi başarısını düşürdüğünü ifade ederek, “Doğru beslenen, düzenli egzersiz yapan ve kötü alışkanlıklardan uzak duran çiftlerde sağlıklı gebelik şansı artıyor. Tedavi öncesi ve süresince sağlıklı bir yaşam biçimi benimsemek, tedavinin başarısını olumlu şekilde etkiliyor” dedi.
Kötü alışkanlıklar kötü etkiliyor

Tüp bebek tedavisine başvuran çiftlerde en yaygın karşılaşılan hatalardan birinin, kötü alışkanlıklara devam etmek olduğunu belirten Doç. Dr. Akça, “Özellikle sigara ve alkol sperm kalitesi ve hareketliliğini azaltıyor, kadınlarda da yumurta rezervi ve kalitesi üzerinde ciddi hasarlara neden oluyor. Gebelik planlayan çiftler sigara ve alkol gibi kötü alışkanlıkları mutlaka bırakmalı. Tüm vücut hücreleri gibi üreme hücreleri de sağlıklı beslenmeden olumlu etkileniyor. Çiftlerin özellikle sebze, meyve, kuruyemiş, bakliyat ve omega-3 yönünden zengin deniz ürünlerine yönelmeleri gerekiyor. Paketli ve işlenmiş gıdalar, gazlı içecekler ve hazır et ürünlerinden uzak durmalarını öneriyoruz” diye konuştu.
Kilonuzun dengeli olması başarıyı artırıyor

Beden kitle indeksinin de gebelik şansını etkileyen önemli bir unsur olduğunu ifade eden Doç. Akça, “Beden kitle indeksinin 20’nin altında ya da 30’un üzerinde olması başarı şansını düşürüyor. Zayıf bireylerin kilo alması, kilolu bireylerin ise zayıflaması gerekiyor. Ayrıca düzenli egzersiz, özellikle polikistik over sendromu ve insülin direnci olan hastalarda oldukça faydalı. Sağlıklı beslenme alışkanlıkları, düzenli spor, zararlı alışkanlıklardan uzak durmak ve beden kitle indeksinin dengede tutulması, tedavinin başarısı açısından önemli unsurlar. Çiftlerin bu sürece bilinçli şekilde hazırlanması gerekiyor” şeklinde konuştu.
Kaynak video:https://alt.internethaber.com/video-embed/2435739
